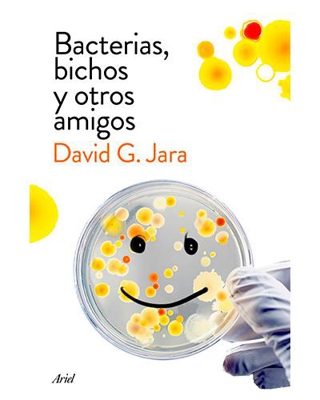
Bacterias, bichos y otros amigos

Comparador de aceites y otros líquidos para coche baratos
801 productos encontrados


Ven y enloquece y otros cuentos de marcianos
Ven y enloquece y otros cuentos de marcianos
Desde22,80 €


El robo del elefante blanco y otros cuentos
El robo del elefante blanco y otros cuentos
Desde10,45 €


La relaxing cup y otros mitos de la marca España
La relaxing cup y otros mitos de la marca España
Desde9,41 €


Al otro lado del espejo y lo que Alicia encontró allí
Al otro lado del espejo y lo que Alicia encontró allí
Desde8,55 €
Shoptize cuenta con cientos de fichas técnicas de aceites y otros líquidos para coche para que tu decisión sea lo más sencilla posible.
Buscamos y comparamos aceites y otros líquidos para coche por ti, simplemente explora nuestra web y filtra según tus propios criterios, encontrarás cientos de aceites y otros líquidos para coche con información cuidadosamente seleccionada para que consigas una compra de 10.
Si quieres economizar tu compra, en Shoptize te ofrecemos una amplia información y comparativa de aceites y otros líquidos para coche
El precio no siempre lo es todo, por eso en Shoptize ofrecemos una gran cantidad de referencias de aceites y otros líquidos para coche de las mejores marcas, para que puedas analizar detenidamente cuál se adapta mejor a lo que estás buscando e incluso donde poder adquirirlo.
Si estás pensando en regalar uno de estos aceites y otros líquidos para coche, antes de apresurarte en la adquisición, date una vuelta por nuestras fichas técnicas de producto para que puedas contrastar las mejores marcas y tengas un acierto seguro.
Compara aceites y otros líquidos para coche, precios y características de diferentes marcas y colecciones.
¿Dudas entre uno de estos aceites y otros líquidos para coche que tanto le gusta a esa persona especial? recorre nuestra sección en la que encontrarás una amplia variedad de aceites y otros líquidos para coche con diferentes precios, cualidades y garantías, escoge el que más te guste y mira su disponibilidad en las diferentes tiendas que estén cerca de tí.
Contamos con un gran catálogo de aceites y otros líquidos para coche de diferentes tiendas, una vez hayas elegido, podrás ver la disponibilidad de ese artículo en alguna de las tiendas. Ahora solo tienes que elegir.
¿Precio?, ¿funcionalidades?, ¿marca? da igual cual sea tu criterio principal a la hora de inclinarte por uno de estos aceites y otros líquidos para coche, en Shoptize puede filtrar en función de tus preferencias para que vayas directo al grano.
Encuentra en Shoptize tu aliado perfecto para comparar aceites y otros líquidos para coche.